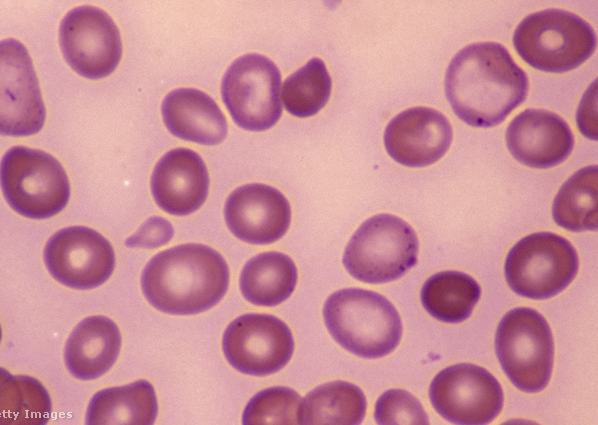

Kiket érint elsősorban, mennyire súlyos betegség, és hogyan előzhető meg vagy kezelhető az anémia?
A vérszegénység nem azt jelenti, hogy kevesebb vérünk van, hanem azt, hogy a vér oxigénszállító fehérjemolekulájának, a hemoglobinnak a mennyisége, illetve a vörösvérsejtek száma jóval a normális érték alá süllyed, aminek következtében a beteg szövetei nem kapnak elegendő oxigént. Tünetei kezdetben enyhék (pl. fáradtság, általános gyengeség), de súlyosabb esetben a letargia kifejezettebbé válik, és sápadtság, szédülés, lábdagadás, lábfájás jelentkezhet.
Vérszegénység több okból is felléphet:
- Hiányos táplálkozás vagy vérvesztés (erős havi vérzés, illetve fekélybetegség vagy rák okozta belső vérzés) esetén alakul ki a vashiányos vérszegénység.
- Ha a vörösvérsejtek gyorsabban esnek szét, mint ahogy pótlódni tudnak (például sarlósejtes anémiánál), hemolitikus vérszegénységről beszélünk.
- A tünetcsport kialakulhat leukémia következtében is, amikor nem termelődik elegendő új vörösvérsejt, ezt nevezik aplasztikus vérszegénységnek.
- Vészes vérszegénység pedig akkor áll be, ha a szervezet nem képes felvenni a B12-vitamint. (A folsavhiány a vészes vérszegénységben tapasztalhatókhoz hasonló tüneteket okoz.)
A hiányzó hemoglobin, illetve a hiányzó vörösvérsejtek megfelelő táplálkozással sok esetben pótolhatók, a vérszegénység ellen azonban a vas- és vitaminkészítmények a leghatásosabbak. A vészes vérszegénységet negyedévenként adott B12-vitamin-injekciókkal gyógyítják.
Nők veszélyben
A folsav- és a B12-vitamin-hiány okozta vérszegénység ritkább, mint a vashiányos vérszegénység, a vegetáriánusoknál és különösen a vegánoknál, akik semmilyen állati eredetű terméket nem esznek, nagy a B12-vitamin-hiány kialakulásának veszélye, ez a vitamin ugyanis a növényi eredetű élelmiszerekből hiányzik. A vegetáriánus terhes asszonyoknál a folsavhiány is viszonylag gyakori probléma.
Bármelyik fajta vérszegénységet állapítják is meg, az alapos orvosi kivizsgálás után felírt vas- vagy folsavtabletták, illetve – vészes vérszegénység esetén – B12-vitamin-injekciók képezik a leghatékonyabb gyógymódot. A legjobb persze, ha lehetőségeink szerint kiegyensúlyozott, vitamindús étrenddel megelőzzük a tünetcsoport kialakulását vagy kiújulását, ehhez az alábbi cikkünkben találsz táplálkozási tippeket:
Mit mivel (nem) érdemes fogyasztani?
A vérszegénység leggyakoribb oka tehát – különösen serdülő lányok és fiatal nők körében – a vashiány, de a kisgyerekek is veszélyeztetettek, mivel tejalapú étrendjükben gyakran nincs elegendő vas.
A vérszegénység tüneteire elsősorban azok számíthatnak, akik kevés vörös húst, belsőséget, szárnyast, halat és zöldséget fogyasztanak. A legtöbb vas a májban van, ám ez terhesség alatt kerülendő, mert az A-vitamin feldúsulását okozhatja, és ezáltal növeli a fejlődési rendellenességek veszélyét. Mivel a vasat a szervezet elég nehezen tudja felvenni, a hiánytünetek megfelelő étrend mellett is jelentkezhetnek. Fontos tudni, hogy a búzakorpában és a barna rizsben lévő fitinsav, valamint a teában lévő tannin gátolja a vas felszívódását, ezért aki hajlamos a vérszegénységre, annak előbbieket egyáltalán, teát pedig étkezéskor nem ajánlott fogyasztania. A dúsított zab- és kukoricapehely viszont megfelelő vasforrás.
Mivel szervezetünk könnyebben veszi fel a vasat az állati eredetű táplálékokból (húsból, halból), mint a levélzöldségekből, a gabonafélékből, a hüvelyesekből és más növényi élelmiszerekből, aki ez utóbbiakból akarja vasszükségletét fedezni, annak ajánlott C-vitaminban gazdag ételeket, például paradicsomsalátát vagy narancslét is fogyasztania, a C-vitamin ugyanis segíti a vas felszívódását. Benned is felmerült, hogy vajon mi történik, ha citromízesítővel felturbózott teát iszol? Jó kérdés, a válasz pedig nyilván attól is függ, hogy mennyi valódi citromot látott az az ízesítő.
































